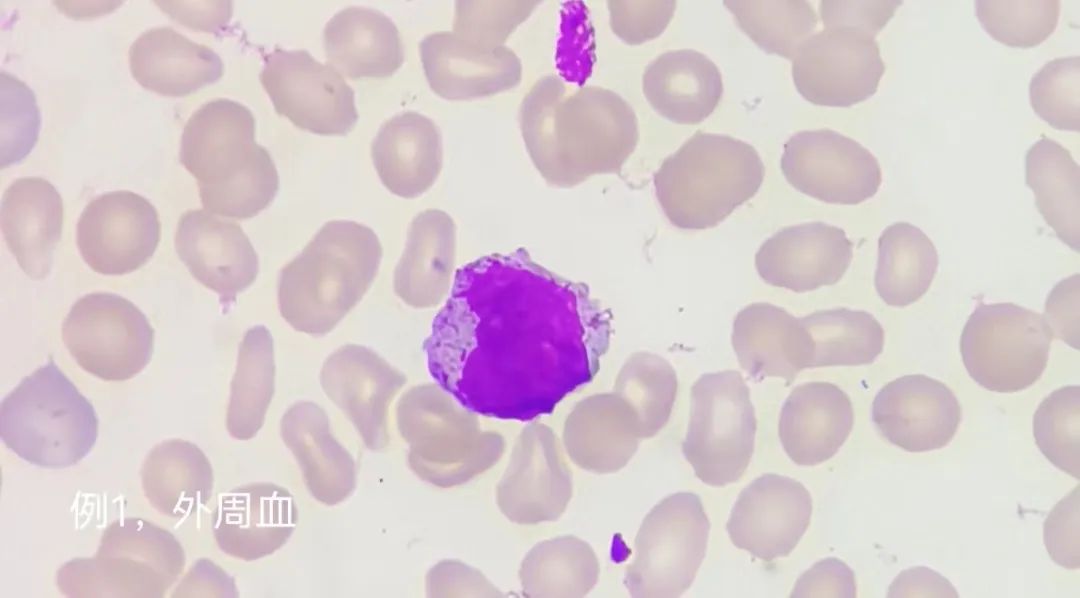

单位 | 三江侗族自治县人民医院检验科
01 前言
急性早幼粒细胞白血病(APL)是一种常见的急性髓细胞白血病,分型标准(FAB分型)为AML-M3型,其特点是以颗粒增多的异常早幼粒细胞异常增生为主,并带有PML-RARA融合基因。有时候,血常规检查会显示三个细胞系的数量减少,其中一些白细胞数量极低,导致外周血的形态学变化很难观察到。有严重出血临床表现和DIC倾向的危险。以2例M3具有不同临床表现进行描述分析。
02 案例经过
病例1
患儿,男,5岁,反复发热,皮下出血,血小板减少,检查肝、门静脉、胆囊、腺、胰腺未见明显异常,实验室检查结果如下:
血常规:白细胞3.3x109/L,红细胞2.74x109/L,血红蛋白87g/L,血小板6x109/L(见图1)。生化检查结果:乳酸脱氢酶372.4U/L,超敏C反应蛋白((hs-CRP)63.24mg/L,其余正常。凝血功能检查结果未见异常。

图1
因不明原因发热,血象三系减少符合骨髓穿刺特征,与家属说明情况后,家属同意行骨髓穿刺,骨髓检查结果如下(见图2)。

图2
骨髓报告分析;异常早幼粒细胞占80.0%,该类细胞核大小不一,胞质少至中等量,呈灰蓝色或灰红色,胞质内充满粗细不一的颗粒,可见柴捆细胞,核类圆形或凹陷折叠。骨髓检查诊断意见考虑AML-M3骨髓象(请结合临床及其他检查)。
病例2
男,60岁,反复发热,乏力,面色苍白,到院急诊科就诊,检查结果如下(图3):

图3
血常规:白细胞0.6x109/L,红细胞2.52x109/L,血红蛋白85g/L,血小板34x109/L。
生化检查:超敏C反应蛋白((hs-CRP)63.3mg/L,血糖(GLU)6.64mmol/L,其余正常。因反复发热,三系减少,肝脾肿大,怀疑白血病,立刻转血液内科诊治,完善检查。凝血功能检查:(见图4)。

图4
凝血酶原时间(PT-sec)15.5ses,凝血酶原时间国际标准(PT-INR)1.26,凝血酶原时间比值(PT-Ratio) 1.29,纤维蛋白(原)降解产物(FDP)19.9ug/mL,D二聚体(D-D)7.08ug/mL,凝血功能异常,存在出血,DIC隐患,风险高。
临床表现符合骨髓穿刺指征,征求患者及家属同意后行骨髓穿刺,骨髓检查结果如下(见图5)。

图5
骨髓报告分析;异常早幼粒细胞占84.5%,该类细胞核大小不一,胞质少至中等量,呈灰蓝色或灰红色,胞质内充满粗细不一的颗粒,可见柴捆细胞,核类圆形或凹陷折叠,核染色质呈粗颗粒状,核仁隐约可见,1-3个。过氧化酶染色:阳性率100%。骨髓诊断意见考虑AML-M3骨髓象(请结合临床及其他检查)。
03 案例分析
2例患者都出现了原因不明的发热,他们的全血细胞三系都有减少,其中病例1没有肝脾肿大,并且凝血功能正常。 该病例中的第二位患者具有肝脾肿大、凝血功能异常和潜在出血DIC风险,由此增加了风险度。
在两个样本的外周血中,发现了很少量的异常早幼粒细胞。而在骨髓涂片中,找到了大量超过80.0%以上的异常早幼粒细胞,它们的胞体较大,内质外浆也明显可见。 有些细胞质中包含数量不同的Auer小体,它们以"柴捆"的方式排列着。 胞核形态可呈"屁股瓣样"或"蝴蝶形"核,折叠并扭曲。 胞质松散细致的污渍,内核清晰可见或模糊(见图6)
图6 病例1,病例2外周血涂片,骨髓涂片均为瑞氏-吉姆萨染色

图7 骨髓涂片,过氧化物酶染色(POX染色),10x100视野
我们在日常工作中也遇到了许多形态不典型的异常早幼粒细胞,有形态介于M2与M3之间,有M3复发出现了规则的原始细胞形态特征等。因此,很多情况下AML-M3的诊断依赖形态与POX染色往往足以诊断[1]。
04 知识延申
根据异常早幼粒细胞外观的特征,将M3白血病分为了粗颗粒型(M3a),细颗粒型(M3b)以及变异型(M3v),粗颗粒型(M3a)是最常见的类型。 三者可以通过细胞化学染色来区分。M3a和M3b的MPO、NAS-DCE、NAS-DAE染色都显示出强阳性,而在加入氟化钠后,NAS-DAE对细胞的抑制作用不明显。PAS染色则呈现出弥散的强阳性。M3v的各项染色结果通常比较不明显,如果不进行细胞化学染色,极易被错误地诊断为急性单核细胞白血病[2]。
05 总结与心得
这是一种以早幼粒细胞分化受阻为主要特征的急性髓系白血病(AML),约占人AML的10%~15%,并发弥散性血管内凝血(DIC)容易造成严重出血倾向,是一种非常危险的白血病[3]。 急性早幼粒细胞白血病是一种恶性疾病,其特点是无限制地增生大量白血病细胞,在骨髓和其他造血组织中繁殖,并进入外周血液。与此同时,正常血细胞的产生明显受到抑制。该病主要发生在年轻人身上。
有时候,一些人在做一般的血常规和凝血功能检查时,可能会出现血象不明显且凝血功能正常的情况,例如病例1,这也许不会立刻让人想到可能是急性早幼粒白血病。 病例2中,有些患者的血常规结果显示白细胞数量极低,且形态学上很难发现早幼粒细胞的异常,因此可能存在漏检的风险。 通过进行骨髓检查可以精确地发现许多异常的早幼粒细胞,并且可以诊断出急性早幼粒细胞白血病。
病因尚未完全明确,病毒可能是重要的致病因素,此外还有放射、化学毒物或药物、遗传物质等许多因素起到辅助的致病作用[4]。 在检验科工作中,我们需要特别关注血常规三系减少时是否可能存在白血病,并且细胞形态检查变得非常重要,它也是考验检验人员专业技能的一项任务。 发现异常早幼粒细胞、Auer小体或柴捆样细胞时,应及时通知临床医生,采取有效措施来控制病情,以挽救更多生命,这也是我们每个医务人员的责任。
参考文献
[1] 朱建锋,浅析异常早幼粒细胞白血病形态特征[J].检验学习网,2017
[2] 王霄霞,夏薇,龚道元临床骨髓细胞检验形态学[M].第一版.北京:人民卫生出版社.2019.
[3] 黄艳萍;肖湘君;冯慧婷;肖义军;急性早幼粒细胞白血病的发病机制与治疗概述[J].生物学教学| 2020.06(038)55-57
[4] 赖燕军;骨髓形态学检查与急性早幼粒白血病的相关性研究[J]黑龙江医药2022.05(016)1040-1042